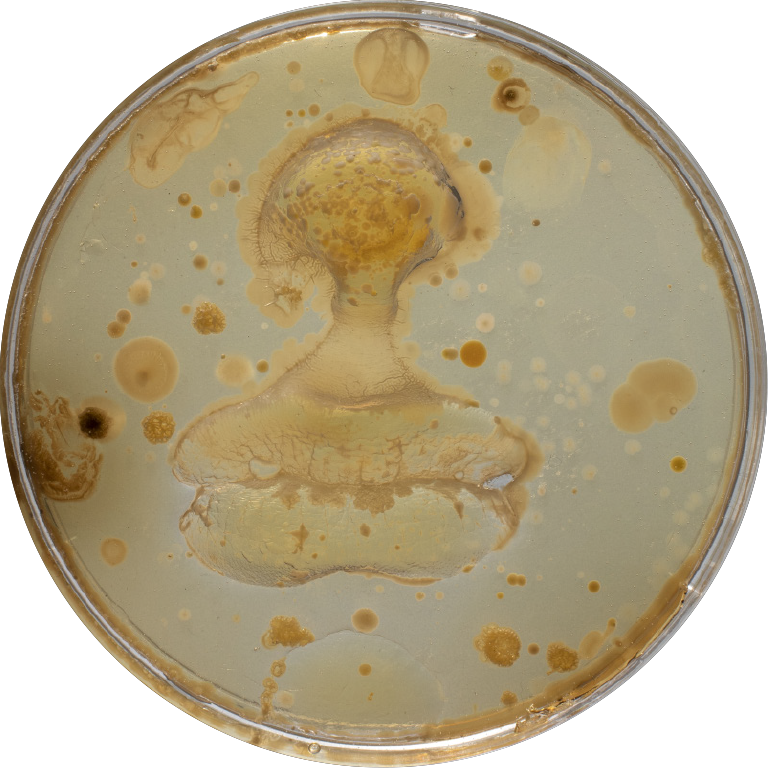
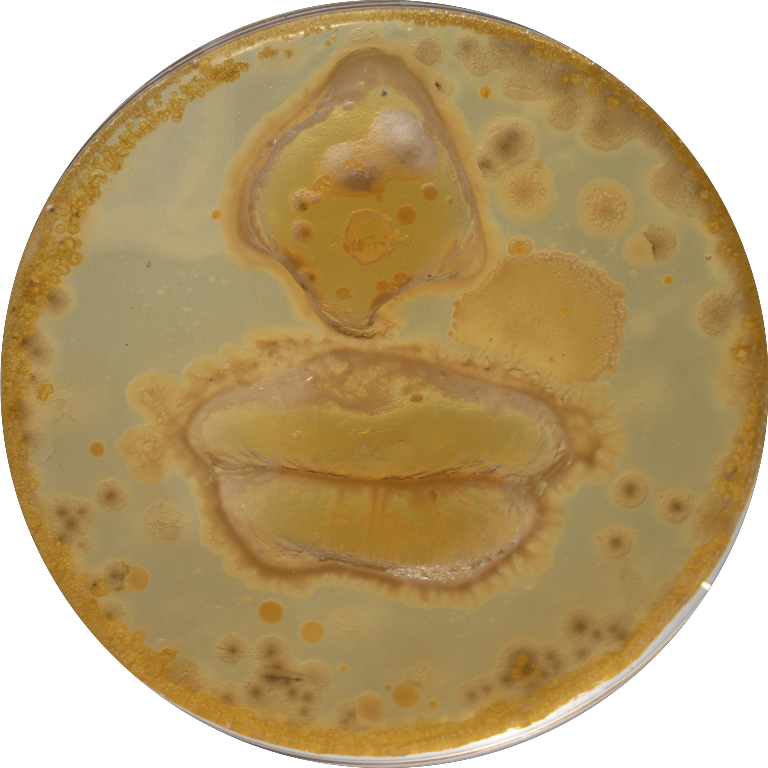

Love Ourself: Me Myself and My Microbiome (2023)
With my final project for the BioHack Academy at Waag, I elaborate on the work BIO-ID LAB, which I created in collaboration with Pim Boreel. In this previous installation, the human microbiome is presented as a new form of identification. Where that study was about differentiating between individuals, this study is more intimate and questions who you are as an individual. Our microbiome, the microbial ecosystem in and on our body, is vital to the well-being of body and mind. We are so intertwined with our microbiome that we wouldn’t exist without it. Can we still see ourselves as individuals, considering this multi-species symbiosis? Are we our microbes? Are our microbes us?
What does it mean to love yourself when you are a multi-species being? As an act of self-love, I ask participants to kiss themselves. By cultivating these kisses, I visualise our intimate connection with our microbiome.